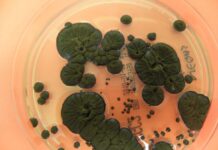

Černobilska gljivica je razvila nevjerovatnu sposobnost kroz jonizirajuće zračenje
Foto: atlasmicologia.blogspot.com Černobiljska zona isključenja možda jeste zabranjena za ljude, ali otkako je reaktor četvrtog bloka u černobiljskoj nuklearnoj elektrani eksplodirao prije skoro 40 godina, drugi oblici života ne samo da su se doselili, već su preživjeli, prilagodili se i izgleda napredovali. Djelimično to može biti zbog nedostatka ljudi, ali za barem jedan organizam, jonizujuće … Nastavi čitati Černobilska gljivica je razvila nevjerovatnu sposobnost kroz jonizirajuće zračenje
0 komentara